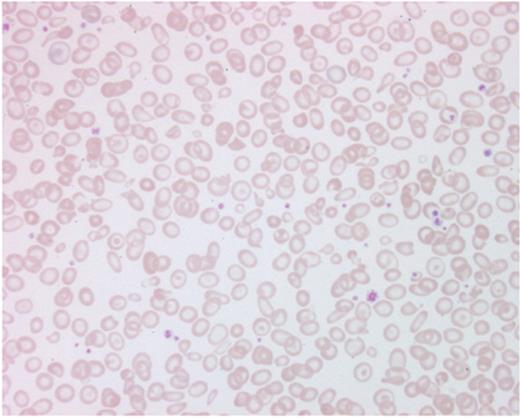
Figure 3. Showing red cell morphology in Hb H disease with hypochromic red cells and numerous anisopoikilocytosis.

Abstract
Hemoglobin H (Hb H) disease is the most common form of thalassemia intermedia and has many features that require careful consideration in management. In the majority of cases, Hb H disease results from double heterozygosity for α0-thalassemia due to deletions that remove both linked α-globin genes on chromosome 16, and deletional α+-thalassemia from single α-globin gene deletions (--/−α). However, Hb H disease may occur from interactions between α0-thalassemia with non-deletional mutations (αTα or αT) or with abnormal hemoglobins such as Hb Constant Spring, Hb Paksé, Hb Quong Sze, and Hb Pak Num Po. In a steady state, patients with Hb H diseases have hemoglobin levels around 9 to 10 g/dL; however, during hemolytic crisis, which frequently develops in or after acute infections with high fever, the hemoglobin level may drop significantly and patients can develop shock or renal shutdown. Even though splenectomy leads to significant elevation of hemoglobin levels, it is not recommended because the majority of patients do well with said steady-state hemoglobin levels. Patients with non-deletional Hb H disease are usually more anemic with significant splenomegaly, and some may require regular blood transfusions and be even as severe as “Hb H hydrops fetalis.” However, there is no clear genotype-phenotype correlation associated with this severe clinical syndrome since patients with identical genotypes do not necessary show the same severity. This suggests that other genetic and environmental factors play a role in modifying the degree of clinical severity in patients with non-deletional Hb H disease.
Hemoglobin H (Hb H) disease is the most severe non-fatal form of α-thalassemia syndrome, mostly caused by molecular defects of the α-globin genes in which α-globin expression is decreased. This condition has long been thought to be a rather mild clinical condition since the majority of patients with Hb H have compensated hemolytic anemia with average hemoglobin levels of more than 9 g/dL. In general, most patients with Hb H rarely require blood transfusion (outside of hemolytic episodes activated by high fever or acute infections), splenectomy or even standard iron chelation therapy, and rarely become transfusion dependent. However, there is increasing evidence that Hb H disease might not be as benign as previously thought, and patients with variations in clinical severity are increasingly observed, especially among those with non-deletional Hb H disease. It is quite possible that other mechanisms may be operating due to the presence of these non-deletional mutations, which could produce unstable α-globin variants, adding red cell pathobiology to the classical presence of precipitated unstable Hb H (β4) from globin chain imbalance. This additional abnormality might be a bona fide cause of increased peripheral hemolysis and ineffective erythropoiesis in such patients, resulting in a more severe clinical phenotype. In this chapter we will review the molecular defects leading to Hb H disease, and its clinical manifestations, diagnosis, and management. We will also discuss possible modifiers at both the genetic and environmental levels that may modify its clinical severity.
Molecular Defects of the α Globin Genes
α-Thalassemia is associated with a variable degree of α-globin chain deficit that reflects the number of the affected α-globin genes. Normal individuals have two α-globin genes (αα) linked on each chromosome 16 with the annotation that the more telomeric copy is designated as the α 2 gene, and adjacent centromeric as the α 1 gene. The majority of mutations that result in complete loss of α-globin production (α0-thalassemia) occur from deletions of the duplicated α-globin genes (--) on one chromosome, previously known as α-thalassemia 1 (α-thal 1).1 All reported α-thal 1 deletions remove both linked α-globin genes interstitially along with different lengths of the adjacent chromosomal contents, from subtelomere to the region beyond the α 1 gene (Figure 1 ). Only a few individuals and families have been found to have the phenotype of α0-thalassemia due to deletions of 40 to 33 kb-upstream DNA sequences (including the ζ-globin gene) and minimal consensus sequences (MCS). MCS are highly conserved throughout evolution and are denoted as hypersensitive site HS-40 and −33. This minimal region of 13 kb is thought to contain a remote regulatory element encompassing most, but not all, cognate binding sites for erythroid-specific transcription factors critical for full α-globin gene expression (Figure 2 ), and removal of this DNA region has been shown to cause a down-regulation of the downstream α-globin genes.2 Therefore, we would like to suggest that the molecular basis of α0-thalassemia can be classified into two categories: (1) interstitial deletional α0-thalassemia caused by deletions that remove both linked α globin genes (previously known as α-thalassemia 1), and (2) upstream-deletional α0-thalassemia with both α-globin genes intact.
Since deletional α0-thalassemia (α-thal 1) is highly prevalent in the Far East, particularly in the southern part of China, Thailand, the Malaysian peninsula and even in the remote islands of the Philippines with carrier rates of 15%, 2.2% to 9%, 4.5% and 5%, respectively, homozygosity of these deleted alleles is not uncommon (--/--).3–5 Due to the complete lack of α-globin gene production, most affected individuals with homozygous α-thal 1, with only a few exceptions, perish at the fetal state or not beyond the third trimester of gestation. Known as Hb Bart’s hydrops fetalis, due to the presence of tetrameric unbound β-like fetal globin chains (γ4), this syndrome could be considered the most severe form of thalassemia. In Southeast Asia and the southern part of China, α-thal 1 mostly occurs from a deletion of about 19.3 kb of the DNA, removing both linked α-globin genes but leaving the ζ gene, an embryonic α-like globin gene intact (--SEA). Another form of α-thal 1 found in this region is the THAI deletion (--THAI), which removes a larger DNA segment (33.5 kb) including the embryonic ζ-globin genes with a significant lower frequency (SEA:THAI = 99:1). Although the different forms of α-thalassemia alleles have a worldwide distribution, the occurrence of Hb Bart’s hydrops fetalis is almost solely confined to this region where the highest incidence of α-thal 1 exists.1
Reduced, but not eliminated, α-globin gene expression known as α+-thalassemia can be caused by either deletional (−α) or non-deletional mechanisms (αTα or ααT). Two common types of deletional α+-thalassemia (previously known as α-thalassemia 2; α-thal 2) have been identified, one involving a deletion of 4.2 kb of DNA (leftward type, −α4.2) and another of 3.7 kb (rightward type, −α3.7). The −α4.2 deletion is present at low frequency in Thailand and Southeast Asian countries,4 but it is more frequent in Papua New Guinea and Vanuatu in Melanesia. The high frequency and worldwide distribution of both deleted alleles suggested that these mutations are quite ancient in the modern human history, and they have aged enough to acquire (although not always) additional nucleotide mutations causing several α-globin chain variants occurring on the chromosomes with the −α3.7 or −α4.2 type deletions. Of these, Hb Q-Mahidol (Thailand) in Thai and Chinese, Hb G-Philadelphia in the African-American population and Hb J-Tonkarigi in the Pacific Islands were found at a higher frequency than other α-globin variants linked with the α-thal 2 deletion.
Nearly 70 different types of non-deletional α+-thalassemia have been reported, most of which are extremely rare and have been reported only in sporadic families (Table 1 ). The majority of these mutations have been found to involve the α 2 genes located in closer proximity to the regulatory region (HS-40 and HS-33), resulting in a higher expressed output than its downstream counterpart (α 1 gene) with a ratio around 3:1. More preferential mutations occurring on α 2 genes might not imply that this leftward-most allele is more susceptible to mutagenesis since both α genes are in close proximity, sharing a similar chromosomal context, but it is plausible that due to a higher contribution of the α 2 gene on globin synthesis, mutated alleles could have a larger effect on phenotypic expression as affected individuals will present with more severe hematological phenotypes.
Although most non-deletional α+-thalassemias are rare, several mutations have been found to be prevalent within specific populations.6–8 Non-deletional mutations, in general, affect the fundamental processes of globin gene expression, from mRNA transcription, splicing and protein translation through creating novel truncated or elongated globin peptides. For example, polyadenylation (poly A) signal mutations (due to different base substitutions or base deletions) in the α2-globin gene are found at high frequencies in Greece, Saudi Arabia and Turkey. Other non-deletional α-thal 2 mutations found at low frequencies in various populations include Hb Constant Spring (CS), Hb Koya Dora and Hb Paksé, which are caused by mutations in the termination codon of the α2-globin gene that result in an elongated polypeptide.8 Hb CS appears to be the most prevalent since it has been identified in several populations from Southeast Asia to China and even the Mediterranean.4,6 The αCS-globin mRNA is unstable and only small amounts of Hb CS are generally produced. This variant has been found to be quite frequent in Southeast Asia (1%–2% in Northeastern Thailand and 5%–8% in southern China). However, Hb Koya Dora appears to be more population specific as it was found at 10% incidence in the Koya Dora tribe from Andhra Pradesh in India.
Molecular Basis of Hb H Disease1
Compound heterozygotes for α0- and α+-thalassemia (--/−α) with only one functional α globin gene have a severe imbalance in globin chain synthesis. The excess β globin chains precipitate and form a characteristic abnormal hemoglobin; hemoglobin H (Hb H) or β globin tetramer (β4). This causes a phenotype of mild to moderate chronic hemolytic anemia named Hb H disease characterized by readily detectable Hb H inclusion bodies in the peripheral blood cells.
Alternatively, Hb H disease can result from the interaction between α0-thalassemia and non-deletional α thalassemia (--/αTα or --/ααT). The deficit in α-globin expression in these Hb H patients (--/αTα) appears to be greater than in the deletional forms of Hb H disease (--/−), and sometimes the non-deletional mutations have additional deleterious effects on terminal erythroid differentiation and red cell metabolism. For example, Hemoglobin Suan-Dok (α2–109 Leu→Arg α2) is a less common α-globin variant occurring from a missense mutation (T→G) in codon 109 in the α 2 gene. Patients with compound heterozygotes of α thal 1 and Hb Suan-Dok have severe symptoms. The thalassemic phenotype associated with the Suan-Dok mutation results from a significant instability of the αSD globin and might lead to aggravated proteolytic activities and apoptosis in affected erythroid cells. This additional pathology might also be operative in Hb Pak Num Po (Hb PNP) caused by codon 132, T insertion of the α 1 gene. Although the α 1 gene is expressed at only one third of the level of the α 2 gene, the interaction of this α 1 mutation and the SEA deletion gives rise to a very severe thalassemia phenotype similar to that of β-thalassemia major.
The clinical phenotypes of Hb H disease found in non-deletional α-thalassemia (--/αTα) are often more severe than those caused by α+-thalassemia resulting from simple deletion (--/−α). Recent molecular analysis of more than 500 thalassemia carriers at the Department of Pediatrics, Siriraj Hospital, Thailand, revealed that the frequency of deletional α thalassemia is significantly higher compared with non-deletional mutations (mainly Hb CS and Pakse) in the general Thai population (15%–20% vs 1%–2%, respectively). However, the number of symptomatic patients with Hb H disease due to non-deletional mutations appeared to be higher than those with deletional Hb H (60% vs 40% from 350 Hb H disease patients), as shown in Table 1 , suggesting that non-deletional Hb H patients have more significant clinical symptoms and require more medical attention. Moreover, this analysis has further extended the molecular spectrum underlying Hb H disease in an Asian population, which appears to be more heterogeneous than previously thought.
In addition, homozygosity for non-deletional α+-thalassemia could result in the Hb H disease phenotype. For example, the homozygous poly (A) mutation is a common cause of Hb H disease among the populations of the Middle East and Central Asia, where this mutation is highly prevalent.9 Homozygosity for Hb Constant Spring and for Hb Koya Dora appear to cause a milder thalassemia syndrome. However, a few emerging cases have suggested that it might not always be the case, as some have been found to be quite as serious as Hb H hydrops fetalis.10
Patients with Hb H disease may also carry β-thalassemia genes because the β-globin gene is on chromosome 11. Hbs AE Bart’s disease occurs from the genotype of Hb H disease plus Hb E trait (--/−α, β/βE) and Hbs EF Bart’s disease occurs from combination of four abnormal genes, either (--/−α + βE/βE or --/−α + β0-thalassemia/βE). This is a relatively common genotype that manifests as thalassemia intermedia with hemoglobin levels between 7 and 8 g/dL.
Clinical Manifestation in Hb H Disease
It is widely accepted when comparing patients with non-deletional and deletional Hb H disease that the former group have lower levels of Hb and higher levels of Hb H and some of them are transfusion dependent, whereas patients in the latter group rarely require regular transfusion.6 This observation has been reproduced in many studies from several populations including Thai, Chinese, Italian, Greek and Middle Eastern, although with different underlying mutations causing the non-deletional Hb H disease.4–6 In general, the majority of patients with Hb H, particularly deletional ones, have rather normal growth and development. Table 2 summarizes the clinical manifestation of two common genotypes of Hb H diseases. Many deletional Hb H patients were first diagnosed as a result of infection/inflammation-induced hemolysis. Jaundice is uncommon, except during hemolytic crisis, and about 38% of Hb H patients have silent gallstones. However, the patients may develop acute and chronic cholecystitis with or without known gallstones. Chronic cholecystitis is very difficult to diagnose based upon the clinical symptoms only. Thus it is investigating patient with thalassemia, including Hb H cases, with “peptic ulcer–like” symptoms by ultrasonography is recommended if they do not respond well to treatment for the ulcer.11
While the clinical phenotype in patients with deletional Hb H disease seems to be homogeneous, the clinical course of non-deletional Hb H disease appears to be remarkably variable, even among patients who have identical genotypes. At one end of the spectrum, some individuals with Hb H disease have never sought medical consultation and are only identified during the course of investigation for other reasons (eg, before routine surgery). In those who do seek medical attention, the frequency of complications and requirement for blood transfusion varies considerably. In an adult population, less than 15% of non-deletional Hb H has growth retardation. However, growth retardation was more common in severe genotypes such as Hb H/Pak Num Po.12 Hepatosplenomegaly is also more common in non-deletional Hb H disease.12
At its most extreme severity, some infants with Hb H disease die in the neonatal period from profound anemia and hydrops fetalis (Hb H hydrops fetalis). The pathophysiologic basis for the variable clinical course between individuals remains unclear. Although this rare condition could be more associated with rare and severe mutations such as codon 30 deletion, codon 31 G→A and codon 59 G→A or Hb Adana-like,13 increasing data have shown that this severe condition might have also been caused by more common non-deletional mutations including poly (A),9 Hb Quong Sze14 or even Hb Constant Spring.15
Our recent analysis of 145 pediatric patients with Hb H Constant Spring has shown that the clinical severity of this syndrome is widely variable. Around 25% of patients with Hb H Constant Spring could be classified as having a more severe phenotype since they had lower baseline Hb levels, required frequent transfusions and eventually underwent splenectomy by 6 years of age. However, many patients with Hb H Constant Spring do not require splenectomy or have never received transfusion and compensate quite well, achieving normal growth and pubertal development. But other patients with an identical genotype may have a more severe phenotype and require intensive management. In conclusion Hb H/CS has provided a good example of non-deletional Hb H syndrome; however, it remains difficult to predict who will have a mild or severe clinical course.
Diagnosis16
Laboratory tests for the diagnosis of Hb H disease include CBC, hemoglobin and DNA analysis. Patients have low red cell parameters such as MCV, MCH and very wide RDW. Red cell shape changes are the same as for other thalassemic diseases (Figure 3 ). Red cell inclusion bodies can be observed in the majority of RBC after exposure to supravital staining dyes such as methylene blue or brilliant cresyl blue (Figure 4 ). Hemoglobin types are A+H (Hb H 5%–25%) with small amounts of Hb Bart’s. Hemoglobin profile in Hb H disease with Hb CS (or Hb Paksé)8 (--/αCSα or --/αPSα) have a similar pattern as those of classical Hb H (--/−α) with the exception that Hb CS is present in minute amounts (Figures 5–7Figure 6,Figure 7 ).17 Because it is present in such small amounts Hb CS is very often undetectable.
Management10,18
Because Hb H patients, in general, have rather high hemoglobin levels (8–9 g/dL) they do not need regular blood transfusion or iron chelation. Supplementation with folic acid (2–5 mg/day) is generally recommended, especially in pediatric patients who may not acquire enough elements for increased erythropoiesis from their daily food.
With hemolytic crisis (frequently during or after acute infections and high fever) the hemoglobin levels may drop to 3 g/dL overnight because the red cells with precipitated Hb H are rapidly destroyed.19 The acute hemolytic crisis may be as brisk as that found in G-6-PD deficiency. The patients can go into shock with acute renal failure. This is probably the only major complication in Hb H disease that requires immediate intervention. When it occurs, blood transfusions and treatment for infections should be promptly administered. Table 3 summarizes guidelines for the management of Hb H disease with hemolytic crisis.
Even though it is rarely reported, aplastic crisis due to infection of Parvovirus B19 may occur in patients with Hb H disease.20 This virus targets active hematopoietic cells, particularly erythroblasts, and results in selective disruption of erythropoiesis.21,22 This condition should be considered in Hb H patients who develop acute anemia and have reticulocytopenia to differentiate it from acute hemolysis. The white blood cells and platelet counts may also be reduced.23 The diagnosis of parvoviral infection requires viral serology test or demonstration of the virus by DNA technology.23 In general, Parvovirus B19 infection is self-limited and usually resolves spontaneously, although some may require blood transfusion support. In cases with chronic infection and prolonged hematopoietic suppression, specific treatment with intravenous immunoglobulin should be considered.23
Although splenectomy is always followed by significant elevation of hemoglobin levels in Hb H disease, it is not generally recommended because most patients do well with said hemoglobin levels in a steady state. Patients with non-deletional Hb H disease who have a more severe clinical phenotype (with baseline Hb < 7 g/dL) may have significant hepatosplenomegaly with or without hypersplenism, abdominal discomfort, and growth retardation and require frequent transfusion (10–12 transfusions per year); in these circumstances, splenectomy might be considered. Some preventative measures, such as pneumococcal vaccine and low-dose aspirin prophylaxis in cases with post-splenectomy thrombocytosis (platelet counts > 1,000,000/mm3) should be considered to avoid post-splenectomy consequences such as overwhelming bacterial infections and venous thrombosis.24
In patients with severe non-deletional Hb H disease, such as Hb H/QZ, Hb H/PNP and other Hb H hydrops that are as severe as β-thalassemia major, may need regular transfusions to maintain baseline pre-transfusion Hb > 9 g/dL.12 In patients who receive regular blood transfusion, a close monitoring of iron overload should be done and appropriate iron chelation therapy should be given when the serum ferritin has reached 1000 ng/mL. In those severe cases, curative therapy by the stem cell transplantation from an appropriately matched donor should be considered.
Gallstones, including intrahepatic bile duct stones, are detected in over 30% of asymptomatic patients with Hb H disease, which can cause abdominal discomfort and hepatobiliary infection.11 Ascending cholangitis does occur in some patients and requires appropriate management including intravenous antibiotics and surgical removal of the stones.
Disease Modifiers
Genetic Modifiers
Although Hb H disease appeared to be the most common thalassemia disease worldwide, little attention has been paid to the clinical heterogeneity of this syndrome. In β-thalassemia disease, considerable effort has been put into a search for the “holy grail” of disease modifying genes, particularly quantitative trait locus (QTL) linked to a high propensity for postnatal γ globin gene expression; however, little progress has been made in the search for genetic modifiers in Hb H. Most studies in Hb H disease follow in the footsteps of those in β-thalassemia, such as the role of the HFE polymorphism25–27 and the UGT1 variants on the risk of hyperbilirubinemia and gallstone development.28–30 However, such studies have not shed any light on understanding the complicated genotype-phenotype correlation, particularly in cases with non-deletional Hb H disease. In clinical practice, these studies merely suggest the risk of possible related complications with little clinical application.
Symptoms in individuals with deletional Hb H disease (--/−α) and coinheritance β-thalassemia trait could well be mild and rarely diagnosed due to the lack of Hb H in the peripheral blood cells.31,32 Hb H disease in some patients, especially those with non-deletional forms, might not be ameliorated by reduced “free β-globin chains.” For instance, Hb H/CS patients with Hb E trait (known as Hb AE Bart’s disease)33 can be varied in terms of clinical severity, similar to cases with simple Hb H/CS, and it is not necessarily as benign a disease as one would expect.
Further reduction of the α-globin gene expression from the remaining allele (the α 1 gene of the non-deletional chromosome 16; --/αTα) could be viable possibility in cases with a more severe phenotype. Mutations of the DNA binding or helicase domains of the ATRX gene on chromosome X caused a rare α thalassemia mental retardation x-linked recessive trait.34,35 Intriguingly, the affected male patients who have four intact α-globin genes also presented with α-globin chain deficiency and Hb H production, suggesting that ATRX play a significant role on α, but not β, globin gene expression.36 In this regard, functional polymorphisms of the ATRX gene, which can further down-regulate α-globin expression, might be obvious candidates.
It is quite likely that the variations in clinical severity with non-deletional Hb H might involve mechanisms other than globin chain imbalance. In particular, those related to altered proteolytic activity, apoptosis, red cell membrane integrity and the alpha hemoglobin specific cytosolic chaperone, alpha hemoglobin stabilizing protein (AHSP).37,38 These cellular systems and their related proteins and partners seem to be prime candidates for future analysis. However, a non-hypothetic, non-directive approach such as GWAS (genome-wide association study) might be a better approach to identify possible genetic modifiers underlying this complex genotype-phenotype correlation of non-deletional Hb H disease with minimal prejudice. Unfortunately, however, no such study has been conducted so far.
Environmental Factors
Acute hemolytic episodes are more common in the first decade of life and may contribute to the clinical severity in Hb H patients. Acute hemolysis appears to decrease in frequency after the second decade of life, with most patients requiring no further transfusions by the time they reach puberty. It has been suggested that acute hemolytic episodes are associated, or partially caused by, concurrent infection and raised body temperature.39 There would be an increased risk of hemolytic crises when the patients were young because children are more susceptible to infection due to their underdeveloped immunity. In addition, recurrent infectious episodes might result in a hyperemic and active splenic function. Splenic expansion due to infections could entrap more red blood cells and worsen the anemic condition. Intercurrent infection, ie, virus, bacteria, malaria and fungi, could initiate a “vicious” cycle of spleen activation, resulting in overt and deteriorating hemolysis in non-deletional Hb H.
In addition, perinatal and intra-partum infection with specific agents such as Parvovirus B19 might be a cause of severe anemia in utero in some infants with Hb H disease.40 Therefore, this might suggest a substantial contribution of environmental factors upon the clinical progression in patients with Hb H disease.
Conclusion
The complex interaction between genetic and environmental factors is troublesome in the efficient long-term management of each patient. One drawback is the lack of comprehensive analysis of the natural history and long-term complications in patients with Hb H disease. A longitudinal picture of patients with Hb H disease from infancy through childhood into adolescence and adulthood may provide greater insight regarding the prediction of the clinical course and natural history of Hb H disease in future cases. This will eventually lead to a better standards of care and management in patients with this syndrome.
Genetic heterogeneity of deletion and non-deletional Hb H disease in 355 Thai pediatric patients.
| Genotypes . | Number . | % . |
|---|---|---|
| Note: The majority of non-deletional mutations affect the α 2 gene, including two termination codon mutations: CS (Hb Constant Spring; TAA-CAA) and PS (Hb Paksé; TAA-TAT), Hb Q-Thailand; α74 Asp→His (GAC-CAC) in the α 4.2 hybrid gene, QS; Hb Quong Sze; α125 Leu→Pro (CTG-CCG), polyA signal (AATAA→AATA--) and intiation codon (ATG→A-G) mutations. PNP (Hb Pak Num Po: T insertion after codon 131) is the only α 1 gene mutation. | ||
| Deletional Hb H disease | ||
| --SEA/−α3.7 | 135 | 43.66 |
| --SEA/−α4.2 | 5 | 1.42 |
| --THAI/−α3.7 | 1 | 0.28 |
| --SEA/−α4.2(Q-Thailand) | 1 | 0.28 |
| Total | 142 | 40 |
| Non-deletional Hb H disease | ||
| --SEA/αCSα | 181 | 51 |
| --SEA/αPSα | 23 | 6.48 |
| --SEA/ααPNP | 3 | 0.84 |
| --SEA/αQSα | 2 | 0.56 |
| --THAI/αCSα | 1 | 0.28 |
| --SEA/αintA-Gα | 1 | 0.28 |
| --SEA/αAATA--α | 1 | 0.28 |
| --SEA/(αα)unknown | 1 | 0.28 |
| Total | 213 | 60 |
| Genotypes . | Number . | % . |
|---|---|---|
| Note: The majority of non-deletional mutations affect the α 2 gene, including two termination codon mutations: CS (Hb Constant Spring; TAA-CAA) and PS (Hb Paksé; TAA-TAT), Hb Q-Thailand; α74 Asp→His (GAC-CAC) in the α 4.2 hybrid gene, QS; Hb Quong Sze; α125 Leu→Pro (CTG-CCG), polyA signal (AATAA→AATA--) and intiation codon (ATG→A-G) mutations. PNP (Hb Pak Num Po: T insertion after codon 131) is the only α 1 gene mutation. | ||
| Deletional Hb H disease | ||
| --SEA/−α3.7 | 135 | 43.66 |
| --SEA/−α4.2 | 5 | 1.42 |
| --THAI/−α3.7 | 1 | 0.28 |
| --SEA/−α4.2(Q-Thailand) | 1 | 0.28 |
| Total | 142 | 40 |
| Non-deletional Hb H disease | ||
| --SEA/αCSα | 181 | 51 |
| --SEA/αPSα | 23 | 6.48 |
| --SEA/ααPNP | 3 | 0.84 |
| --SEA/αQSα | 2 | 0.56 |
| --THAI/αCSα | 1 | 0.28 |
| --SEA/αintA-Gα | 1 | 0.28 |
| --SEA/αAATA--α | 1 | 0.28 |
| --SEA/(αα)unknown | 1 | 0.28 |
| Total | 213 | 60 |
The clinical manifestation of classic Hb H disease versus Hb H disease with Hb Constant Spring or Hb Paksé (Hb CS and PS).
| Clinical manifestation . | Hb H (--/−α) . | Hb H-Hb CS and PS (--/αCSα and --/αPSα) . |
|---|---|---|
| Number | 125 | 145 |
| Age at first transfusion (y) | 11 ± 5.5 | 1.5 ± 2.1 |
| History blood transfusion | 29% | 50% |
| Age of 1st transfusion | 12 ± 4.5 | 3 ± 2.5 |
| Growth retardation | Rare | 15% |
| Anemia | 58% | 65% |
| Jaundice | 24% | 27% |
| Hepatomegaly | 6% | 11% |
| Splenomegaly | 15% | 24% |
| Gallstones | 10% | 28% |
| Clinical manifestation . | Hb H (--/−α) . | Hb H-Hb CS and PS (--/αCSα and --/αPSα) . |
|---|---|---|
| Number | 125 | 145 |
| Age at first transfusion (y) | 11 ± 5.5 | 1.5 ± 2.1 |
| History blood transfusion | 29% | 50% |
| Age of 1st transfusion | 12 ± 4.5 | 3 ± 2.5 |
| Growth retardation | Rare | 15% |
| Anemia | 58% | 65% |
| Jaundice | 24% | 27% |
| Hepatomegaly | 6% | 11% |
| Splenomegaly | 15% | 24% |
| Gallstones | 10% | 28% |
Management of Hb H disease with hemolytic crisis.
|
|
Interstitial deletions causing resulting to different α0 thalassemia and α+ thalassemia (modified from Higgs1)
Interstitial deletions causing resulting to different α0 thalassemia and α+ thalassemia (modified from Higgs1)
Diagram of upstream deletions of the α cluster and their relative positions within chromosome 16p 13.3 (modified from Viprakasit et al. 2003).2
Diagram of upstream deletions of the α cluster and their relative positions within chromosome 16p 13.3 (modified from Viprakasit et al. 2003).2
Showing red cell morphology in Hb H disease with hypochromic red cells and numerous anisopoikilocytosis.
Showing red cell morphology in Hb H disease with hypochromic red cells and numerous anisopoikilocytosis.
Red cell inclusion body was induced after the incubation of red cell with brilliant cresyl blue.
Red cell inclusion body was induced after the incubation of red cell with brilliant cresyl blue.
Starch gel electrophoresis in the alkaline pH 8.6 showing Hb H as a fast moving band.
Starch gel electrophoresis in the alkaline pH 8.6 showing Hb H as a fast moving band.
Hemoglobin analysis of Hb H-Hb CS patient showing Hb Bart’s, Hb H, Hb A, Hb A2, and Hb CS by automated HPLC system (Bio Rad Variant Hemoglobin Analyzer, Hercules, CA).
Hemoglobin analysis of Hb H-Hb CS patient showing Hb Bart’s, Hb H, Hb A, Hb A2, and Hb CS by automated HPLC system (Bio Rad Variant Hemoglobin Analyzer, Hercules, CA).
Hemoglobin analysis in Hb H-Hb CS using capillary zone electrophoresis (Sebia, Inc, Norcross, GA).
Hemoglobin analysis in Hb H-Hb CS using capillary zone electrophoresis (Sebia, Inc, Norcross, GA).
Disclosures Conflict-of-interest disclosure: SF declares no competing financial interests. VV receives research funding and honoraria from Novartis, GPO Thailand, Tri Medical (Thailand) and is on their speakers bureaus and advisory panels. Off-label drug use: None disclosed.
References
Author notes
Thalassemia Research Center, Institute of Molecular Biosciences
Hematology/Oncology Division, Department of Pediatrics, Faculty of Medicine Siriraj Hospital, Mahidol University, Bangkok, Thailand